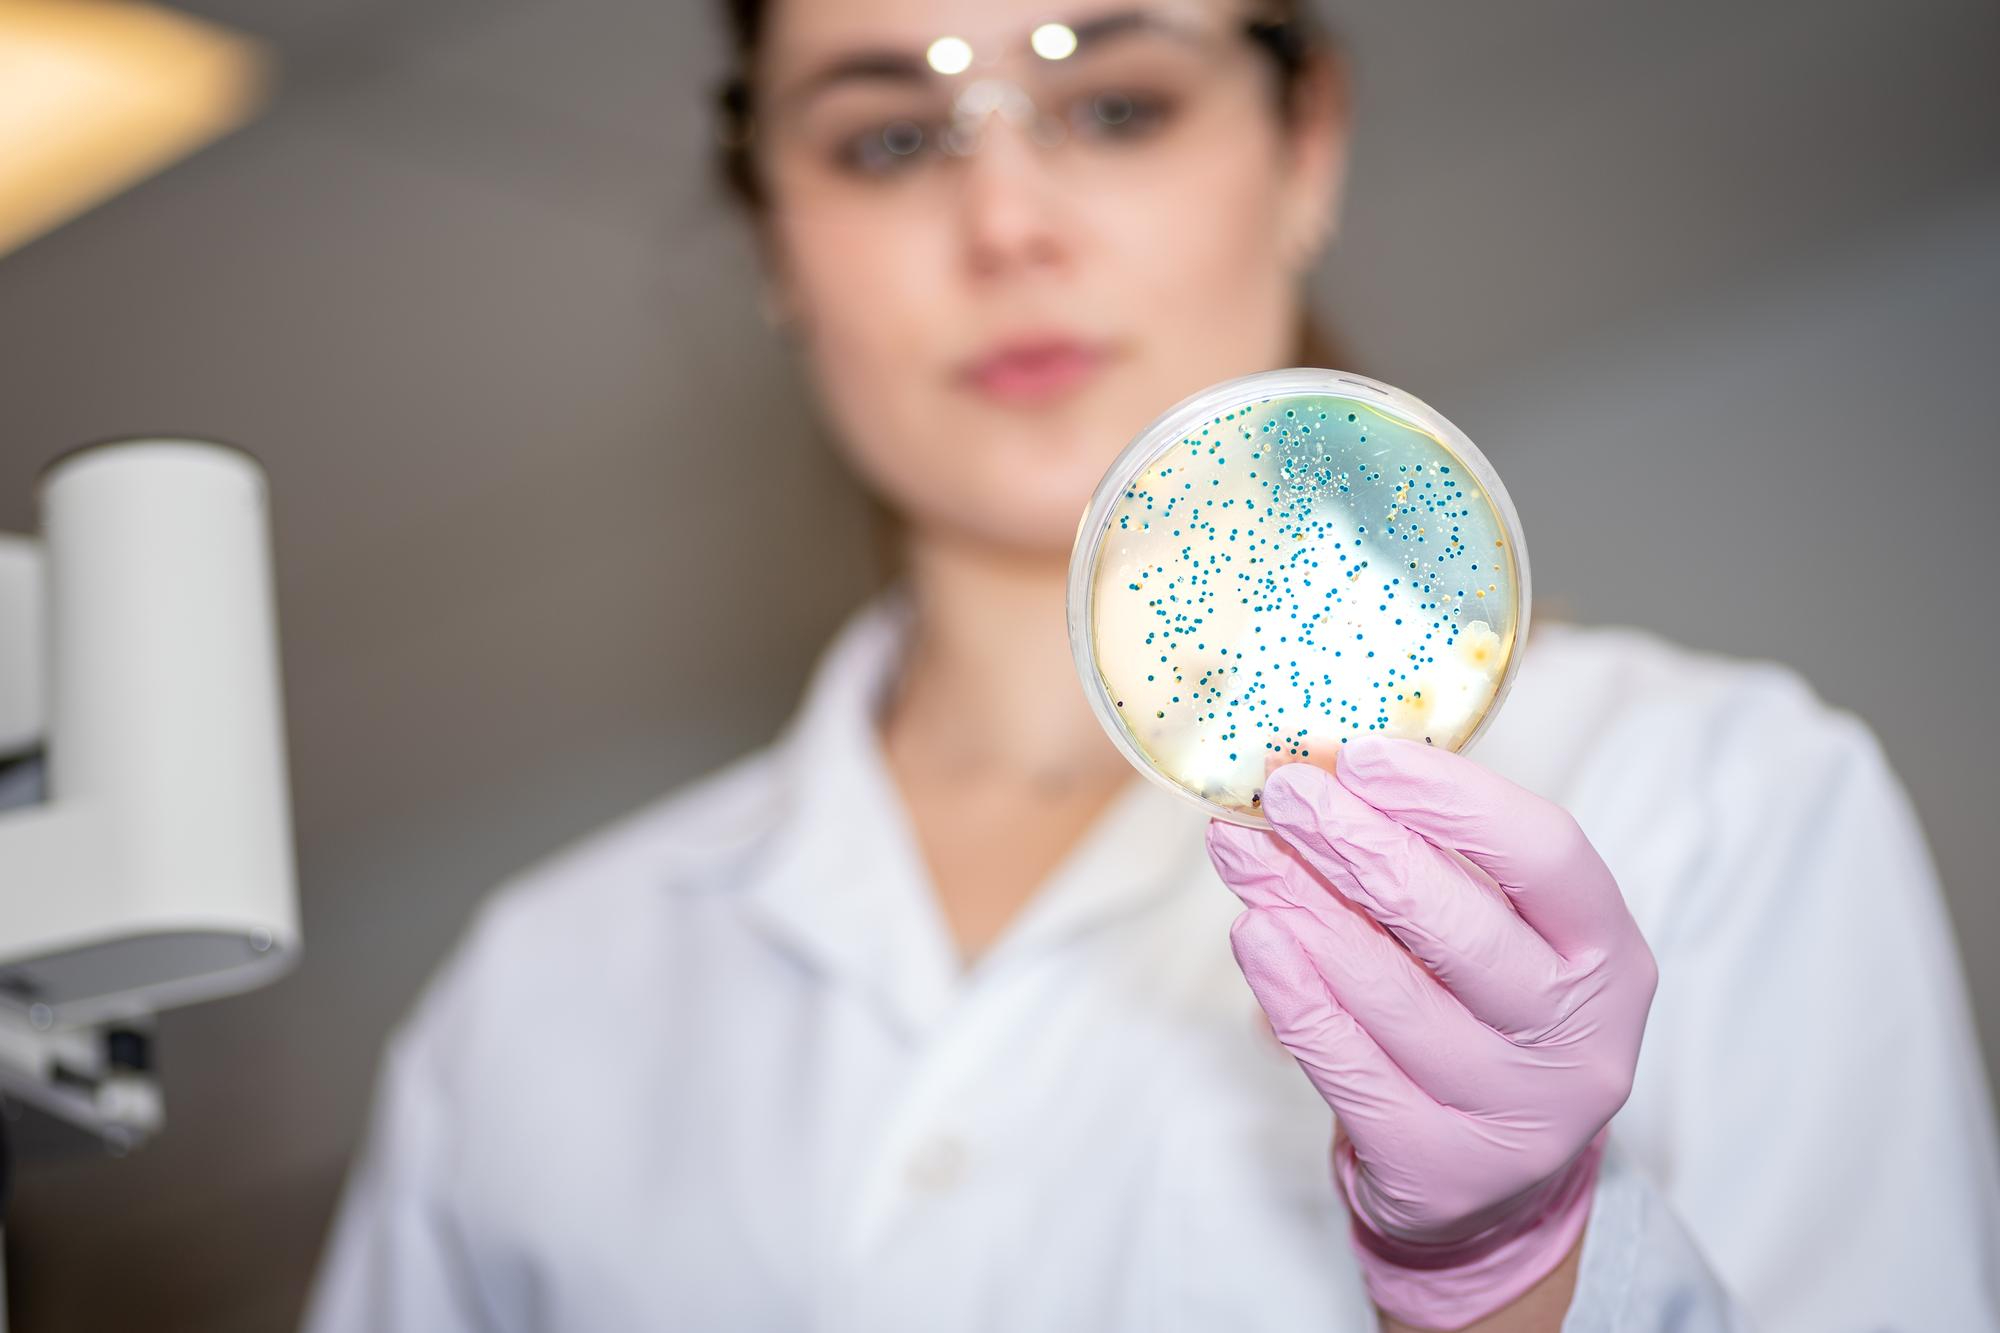
PARASITOS HECES TERCERA MUESTRA

TEST Y ANALÍTICAS
Ponemos a su disposición nuestros servicios de TEST Y ANALÍTICAS
para que los mejores profesionales de QSalud cuiden de ti y de tu familia desde donde quieras.
Recibe atención médica online con nuestros planes médicos. Y, si tienes una urgencia, solicita asistencia médica telefónica de forma inmediata sin necesidad de cita previa.
Busca en Digestivo
ESPECIALIDAD MEDICA

CITA MÉDICA ONLINE
Tramita tu cita médica con el especialista de forma ágil y rápida.

PRECIO EXCLUSIVO DE QSALUD
Aprovecha el precio exclusivo de nuestra web y pide tu consulta presencial con el especialista en la extensa red de hospitales de QSalud.

SIN SALIR DE CASA
Recibe la atención personalizada de nuestros especialistas sin salir de casa gracias a nuestras consultas médicas telefónicas.
PREGUNTAS FRECUENTES
¿Cómo contratar los planes de salud?

1
Contrata el plan que mejor se adapte a ti en QSalud Online.

2

3
Disfruta de los servicios médicos en el área del Mi QSalud Digital dentro de la app de QSalud Online.